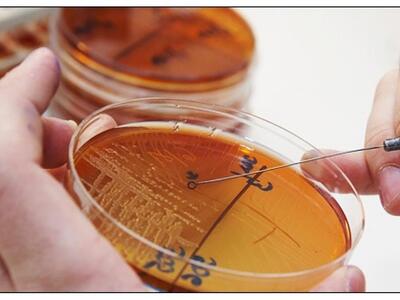
50 καθημερινές ουσίες που "πυροδοτο...

Ειδικά αν συνδυασθούν μεταξύ τους
Πενήντα συνηθισμένες χημικές ουσίες, στις οποίες οι άνθρωποι εκτίθενται καθημερινά, μπορούν να «πυροδοτήσουν» καρκίνο, αν συνδυασθούν μεταξύ τους, ακόμη και σε χαμηλές δόσεις, σύμφωνα με μια νέα μεγάλη διεθνή επιστημονική έρευνα. Είναι η πρώτη φορά που γίνεται σε τέτοια έκταση μια μελέτη για την πιθανή καρκινογόνα δράση των χημικών του περιβάλλοντος.
Η ερευνητική κοινοπραξία, υπό τον συντονισμό της μη κερδοσκοπικής αντικαρκινικής οργάνωσης "Getting To Know Cancer", που εδρεύει στον Καναδά, περιλάμβανε 174 επιστήμονες από ερευνητικά κέντρα σε 28 χώρες, οι οποίοι έκαναν τη σχετική δημοσίευση στο περιοδικό "Carcinogenesis" (Καρκινογένεση).
Οι ερευνητές, με επικεφαλής τον Ουίλιαμ Γκούντσον του Ιατρικού Κέντρου Καλιφόρνιας-Ειρηνικού στο Σαν Φρανσίσκο, μελέτησαν τη σχέση ανάμεσα σε 85 κοινές χημικές ουσίες, που από μόνες τους δεν θεωρούνται καρκινογόνες για τους ανθρώπους. Οι επιστήμονες κατέληξαν στο συμπέρασμα ότι 50 από αυτές τις ουσίες, σε διάφορους συνδυασμούς στο περιβάλλον, μπορούν να συμβάλουν στην εκδήλωση καρκίνου.
«Η έρευνα υποστηρίζει την ιδέα ότι τα χημικά που δεν θεωρούνται επιβλαβή από μόνα τους, όταν συνδυάζονται και αργά συσσωρεύονται στο σώμα μας, μπορούν να πυροδοτήσουν καρκίνο και μπορεί να βρίσκονται πίσω από την παγκόσμια επιδημία καρκίνου, της οποίας είμαστε μάρτυρες. Καθίσταται πια επείγον να αφιερώσουμε περισσότερη προσοχή στις επιπτώσεις που έχει η έκθεση σε χαμηλές δόσεις σε αυτά τα μίγματα χημικών, τα οποία υπάρχουν στο φαγητό που τρώμε, στον αέρια που αναπνέουμε και στο νερό που πίνουμε», δήλωσε ο βιολόγος του καρκίνου δρ Χεμάντ Γιασαέι του Πανεπιστημίου Μπρουνέλ του Λονδίνου.
Με βάση τις μέχρι τώρα έρευνες, οι διάφορες χημικές ουσίες μπορούν να θεωρηθούν υπεύθυνες για έως το 20% των καρκίνων διεθνώς (έναν στους πέντε). Καθώς ο ανθρώπινος πληθυσμός εκτίθεται συνεχώς σε ολοένα περισσότερα χημικά, οι επιστήμονες ζητούν να υπάρξει καλύτερη κατανόηση της πιθανής καρκινογόνου δράσης αρκετών από αυτές τις ουσίες.
Μετά και τη νέα μεγάλη μελέτη, οι επιστήμονες ζητούν να δοθεί μεγαλύτερη έμφαση στην αργή και ύπουλη έκθεση των ανθρώπων σε ποικίλα «κοκτέιλ» διαφόρων φαινομενικά αθώων χημικών ουσιών, οι οποίες όμως, σε συνδυασμό μεταξύ τους, μπορεί να αποβούν καρκινογόνες.
Ακολουθήστε το thebest.gr στο Google News και μάθετε πρώτοι όλες τις ειδήσεις
Δείτε όλες τις τελευταίες Ειδήσεις από την Ελλάδα και τον Κόσμο, τη στιγμή που συμβαίνουν, στο thebest.gr